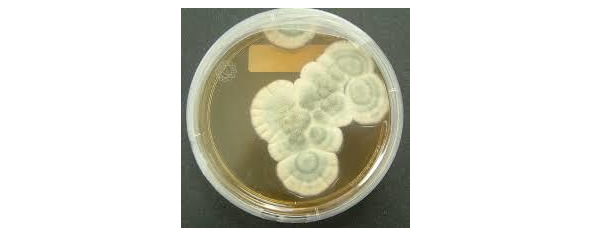

2.1.1. Пенициллин
Пенициллин – первый антибиотик – антимикробный препарат, полученный на основе продуктов жизнедеятельности микроорганизмов.

Рисунок 18. Александр Флеминг
По легенде, его случайно открыл в 1928 году Александр Флеминг. Он занимался исследованиями борьбы с бактериями, и как-то обратил внимание на то, что плесень Penicillium, которая выросла в обычной колбе, угнетает рост колонии бактерий.
Флеминг сделал правильный вывод – плесень Penicillium notatum обладает бактерицидным действием.
Рисунок 19. Колонии плесени Penicillium notatum
Его результаты стали основой работ, Говарда Флори (Howard Florey, 1898—1968) и Эрнста Чейна (Ernst Chain, 1906—79), Оксфордского университета, которые в 1938 году выделили чистую форму пенициллина. А уже в 1941 году была получена первая доза пенициллина, которая спасла жизнь 15-летнему подростку с заражением крови.
Надо понимать, что еще в 1930-х годах десятки тысяч людей умирали от дизентерии, воспаления лёгких, тифа, лёгочной чумы, а сепсис был смертным приговором14.
С началом Второй Мировой войны резко возросла потребность антибиотиках, способных защитить тысячи раненых от заражения крови. Работы над получением пенициллина резко ускорились, и в 1943 году впервые началось промышленное производство пенициллина. Грибок выращивали на курином бульоне, а затем из него получали лекарство.
Раскачиваться времени не было и технология массового выпуска пенициллина, сразу же была передана на предприятия Pfizer и Merck. В середине Второй мировой войны в США производство пенициллина было поставлено на конвейер, что спасло от гангрены и ампутации конечностей десятки тысяч американских и английских солдат.

Рисунок 20. Чаны для выращивания пенициллина
В 1945 году Флемингу, Флори и Чейну была присуждена Нобелевская премия по физиологии и медицине «за открытие пенициллина и его целебного воздействия при различных инфекционных болезнях».
Однако технология выращивания грибка на курином бульоне была крайне дорогостоящей и громоздкой. Нужна была другая технология.
И она появилась! В 1946 г. удалось осуществить синтез пенициллина, который был идентичен природному, полученному биологическим путем. Технология биосинтеза пенициллина позволила многократно снизить стоимость препарата, а главное – она стала основой для получения многих других антибиотиков.
Пенициллин, а затем и другие антибиотики стали доступными во всех странах мира, что спасает жизнь и здоровье миллионам людей.
Более 800 000 книг и аудиокниг! 📚
Получи 2 месяца Литрес Подписки в подарок и наслаждайся неограниченным чтением
ПОЛУЧИТЬ ПОДАРОКДанный текст является ознакомительным фрагментом.